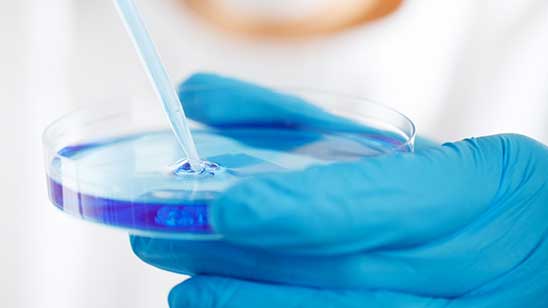
Lassa Fever in Nigeria

Leptospirosis is a worldwide zoonotic disease caused by Gram negative bacteria of the genus Leptospira spp. The taxonomy of Leptospira is complex and it is based on two different classification criteria. Serologically, there are more than 300 leptospiral serovars recognised...
C. Tassinato, E. Mazzotta, L. Lucchese, M.B. Boniotti, C. Bertasio, M. D’Incau, L. Ceglie, L. Bellinati, M. Mazzucato, A. Natale